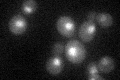
YCR082W
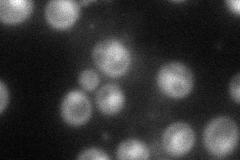
YCR082W
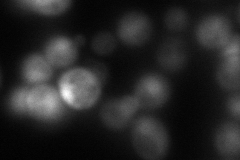
YCR082W
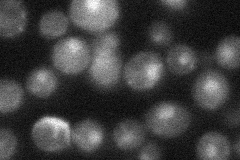
YCR082W
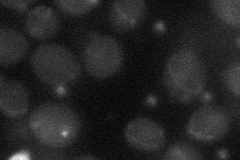
YCR082W

View description
Protein of unknown function, putative transcriptional regulator; proposed to be a Ada Histone acetyltransferase complex component; GFP tagged protein is localized to the cytoplasm and nucleus
Localization:
Intensity:
Fold change:
Significance:
-
C’ GFP library in SD
nucleus29.41 -
N' NOP1pr-GFP in SD
cytosol,nucleus63.6477 -
N' TEF2pr-mCherry in SD
cytosol,nucleus7.19937 -
N' NATIVEpr-GFP in SD
nucleus29.8553 -
N' TEF2pr-VC and Cyto-VN in SD
below threshold22.3896 -
C’ GFP library in SD+DTT

nucleus22.340.75No -
C’ GFP library in SD+H2O2

nucleus25.930.88No -
C’ GFP library in Starvation Media

nucleus21.20.72Yes -
C’ GFP library on the background of Pup2-DaMP

nucleus -
C’ GFP library on the background of CCT mutant

nucleus27.27650.927244No
